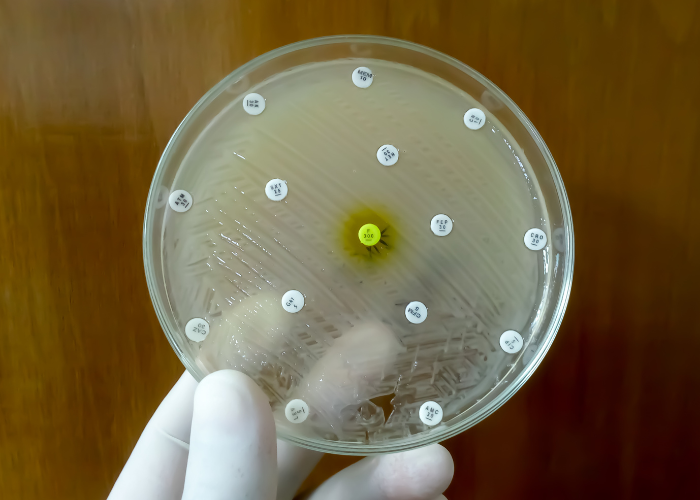
antibiotiaresistente bakterien

Čo sú antibiotiká?
Antibiotiká sú lieky, ktoré pôsobia predovšetkým proti baktériám. V závislosti od typu baktérií môžu byť tieto mikroorganizmy “neškodné” alebo ” škodlivé” a v najhoršom prípade môžu spôsobiť ochorenia. Vtedy môžu antibiotiká pomôcť ľudskému telu bojovať proti týmto choroboplodným zárodkom. Mnohé štúdie však ukazujú, že antibiotiká môžu spôsobovať aj nežiaduce vedľajšie účinky, od hnačky spojenej s antibiotikami, cez opakované infekcie až po alergie.
Aké sú vedľajšie účinky antibiotík?
Vedľajším účinkom antibiotík je okrem iného to, že narušujú črevnú mikrobiotu, ktorá je domovom mnohých “prospešných” baktérií. V nedávnej štúdii sa ukázalo, že po štvordňovej liečbe antibiotikami sa v črevách zdravých ľudí zvýšil počet patogénnych zárodkov. Podľa autorov je to vysvetlenie, prečo môžu antibiotiká spôsobiť aj infekciu baktériou Clostridium difficile (CDI), ktorá nie je úplne neškodná.
Hlavné vedľajšie účinky antibiotík
1. Narušenie črevného mikrobiómu (dysbióza)
Antibiotiká nerozlišujú medzi „zlými“ a „dobrými“ baktériami.
zníženie diverzity črevných baktérií
úbytok prospešných druhov (napr. Lactobacillus, Bifidobacterium)
obnova mikrobiómu môže trvať týždne až mesiace, niekedy aj dlhšie
2. Tráviace ťažkosti
Veľmi časté:
Antibiotikami asociovaná hnačka vzniká práve kvôli narušeniu rovnováhy baktérií.
3. Premnoženie patogénov
Keď „dobré“ baktérie zmiznú, uvoľní sa priestor pre problémové mikroorganizmy:
Clostridioides difficile – môže spôsobiť ťažké zápaly čreva
kvasinky (Candida) – vaginálne mykózy, afty, kožné problémy
4. Oslabenie imunity
Až 70 % imunitného systému sídli v čreve.
častejšie infekcie po antibiotikách
znížená imunita
u detí možný vplyv na vývoj imunity
5. Alergie a precitlivenosť
kožné vyrážky
svrbenie
Skoré a časté užívanie antibiotík zvyšuje riziko alergií a astmy.
6. Metabolické a dlhodobé efekty
Výskum ukazuje súvislosť s:
inzulínovou rezistenciou
zvýšeným rizikom obezity (najmä pri častých ATB v detstve)
7. Rezistencia baktérií
baktérie sa „učia“ prežiť a stávajú sa odolné voči antibiotikám
antibiotiká prestávajú fungovať
veľký globálny zdravotný problém
Ako dlho môžu mať antibiotiká vedľajšie účinky?
Hoci sa črevná mikrobiota skúmaných osôb v uvedenej štúdii približne mesiac a pol po liečbe antibiotikami už z veľkej časti obnovila, deväť bežných bakteriálnych kmeňov, ktoré sú dôležité pre normálnu funkciu črevnej mikrobioty, po šiestich mesiacoch stále chýbalo. Okrem toho vedci zistili u prítomných baktérií zvýšený výskyt génov rezistencie, ktoré dokážu oslabiť alebo dokonca zrušiť účinok antibiotík.
Priberanie ako dôsledok užívania antibiotík
Zdravá črevná mikrobiota je dôležitá pre zdravie a ovplyvňuje celé telo – má vplyv aj na telesnú hmotnosť. Rovnováha črevného mikrobiómu však môže byť užívaním antibiotík vážne narušená. Skupina výskumníkov zistila, že aj šesť mesiacov po podaní antibiotík chýbalo v črevnej mikrobiote deväť bežných bakteriálnych druhov. V dôsledku mikrobiálnych zmien môže dôjsť aj k nárastu hmotnosti. Štúdie ukázali, že osoby, ktoré dostávali antibiotiká, priberali častejšie ako osoby, ktoré neboli liečené. Podobný jav bol pozorovaný aj u detí. Deti, ktoré dostávali antibiotickú liečbu počas prvých 6 mesiacov života, pribrali viac ako deti, ktoré liečbu nedostávali.
Alergie u detí
Liečba antibiotikami by sa mala dobre zvážiť aj u detí a najmä u novorodencov. Nedávna štúdia ukázala, že u bábätiek, ktoré v prvých šiestich mesiacoch života dostávali antibiotiká alebo blokátory kyselín, sa alergie vyskytovali približne dvakrát častejšie ako u detí, ktoré nedostávali žiadny z týchto liekov. V tejto rozsiahlej štúdii bolo pozorovaných približne 800 000 detí od 35. dňa po narodení až do nástupu do materskej školy. Vedcom sa podarilo preukázať, že existuje jasná súvislosť medzi užívaním antibiotík a blokátorov kyselín a alergiami. Ak dieťa trpí infekciou, malo by sa vopred skontrolovať, či má bakteriálnu príčinu. Ak je to tak, malo by sa tiež objasniť, či je užívanie antibiotík naozaj nevyhnutné.
Rezistencia/odolnosť voči antibiotikám
Najmä rozsiahle užívanie antibiotík viedlo k tomu, že baktérie sa stali necitlivými na rôzne účinné látky. To následne sťažuje úspešnú liečbu infekčných ochorení. Čím väčšia je odolnosť baktérií, tým je to ťažšie. Najmä v nemocniciach predstavujú tieto tzv. multirezistentné baktérie osobitnú výzvu.
Austrálski vedci varujú napríklad pred stafylokokom Staphylococcus epidermidis, ktorý je už odolný voči dvom najčastejšie používaným antibiotikám, zvyčajne v kombinácii. Môže spôsobiť závažné infekcie, ktoré môžu byť dokonca smrteľné. Táto baktéria, ktorá je príbuzná baktérii MRSA, sa vyskytuje na ľudskej koži. Môže však viesť k infekciám, najmä u starších ľudí alebo pacientov, ktorí majú implantované protézy. Vedci sa domnievajú, že baktérie sa šíria v dôsledku mimoriadne častého používania antibiotík na jednotkách intenzívnej starostlivosti. Preto sa zdá, že postup, keď sa používa niekoľko liekov naraz, aby sa zabránilo rezistencii, nefunguje. Okrem toho Svetová zdravotnícka organizácia (WHO) už dlho varuje pred nadmerným používaním antibiotík.
Zápaly močových ciest. Je užívanie antibiotík nevyhnutné?

Pri zistení baktérií v moči lekári často predpisujú antibiotiká. Podľa Normy Jungovej, členky poradného výboru DGI (Nemeckej spoločnosti pre infektológiu), však môžu mať baktérie v moči rôzne príčiny a sú častejšie u žien ako u mužov. Liečba antibiotikami by sa mala začať len vtedy, keď sa vyskytnú typické príznaky infekcie močových ciest. Aj v prípade existujúcej infekcie močového mechúra je potrebné zvážiť závažnosť ochorenia. Štúdia ukázala, že približne dve tretiny žien s nekomplikovanými infekciami močových ciest sa uzdravia bez užívania antibiotík. Neuvážené užívanie antibiotík môže spôsobiť opakované zápaly a infekcie, pretože antibiotká ničia aj tie prospešné baktérie v tele. Tak sa začína začarovaný kruh.
Čo robiť, ak je antibiotická liečba nevyhnutná?
Samozrejme, existujú ochorenia, pri ktorých je antibiotická liečba nevyhnutná. V tomto prípade má zmysel dodať črevu dostatok užitočných baktérií, napr. vo forme synbiotík. Hlavným vedľajším a nežiadúcim účinkom antibiotík totiž je, že antibiotiká ničia nielen patogény, ale aj celé kmene životne dôležitých črevných baktérií. Užívaním probiotík telo dostáva “zásoby” vo forme baktérií prirodzene sa vyskytujúcich v ľudskom tele, ktoré sa môžu v čreve usadiť, množiť a plniť svoje dôležité úlohy ako je vstrebávanie živín, imunitná obrana a pod.
Zdroje:
- www.univadis.de/medical-news/173/Infektiologen-Vorsicht-beim-Umgang-mit-Antibiotika
- Palleja A et al. Nat Microbiol 2018; 3: 1255-1265
- www.univadis.de/medical-news/173/Antibiotika-bei-vielen-Blasenentzuendungen-nicht-notwendig
- https://kurier.at/wissen/kein-gegenmittel-gefaehrlicher-superkeim-breitet-sich-aus/400108334
- https://www.univadis.de/viewarticle/allergien-bei-saeuglingen-durch-antibiotika-und-saeureblocker-getriggert-594056
Probiotiká k antibiotikám
Rozsiahle štúdie ukazujú, že OMNI-BiOTiC® 10 AAD dokáže regulovať vedľajšie účinky antibiotickej liečby – konkrétne bakteriálnu dysbalanciu v črevách.

Hlavnou funkciou antibiotík je ničiť mikroorganizmy spôsobujúce choroby. Antibiotiká však bohužiaľ zároveň ničia časti ochrannej črevnej sliznice a poškodzujú prirodzené, zdravé črevné baktérie. Tým sa nebezpečné mikroorganizmy a ich toxíny môžu rýchlo množiť. Toto narušenie rovnováhy v črevách môže následne viesť k rôznym vedľajším účinkom a spôsobiť tak ďalšie alebo opakované ochorenia. Tieto ťažkosti sa môžu objaviť okamžite, alebo až niekoľko týždňov po prvom užití antibiotík. Okrem toho sa pri každom užívaní antibiotík znižuje rozmanitosť bakteriálnych kmeňov v našom čreve. Vysoká rozmanitosť črevných baktérií je však absolútne nevyhnutná na to, aby črevo mohlo bez obmedzenia vykonávať svoje rôznorodé úlohy (napr. rozkladať, vstrebávať a tvoriť živiny, produkovať imunitné bunky, dodávať energiu). Preto pri každej antibiotickej liečbe podporte črevo špeciálne vybranými črevnými baktériami, aby ste znížili vedľajšie účinky antibiotík!
OMNI-BiOTiC® 10 AAD:
- Užívajte počas akejkoľvek liečby antibiotikami
- Osídľuje črevá 10 vedecky vybranými bakteriálnymi kmeňmi
- Obsiahnuté bakteriálne kmene sa trvalo usadia v čreve
- Zabraňuje rozmnožovaniu baktérií, ako je Clostridium difficile
- Znižuje uvoľňovanie toxínov baktérií Clostridium difficil
- Neobsahuje živočíšne bielkoviny, glutén, kvasnice a laktózu











































